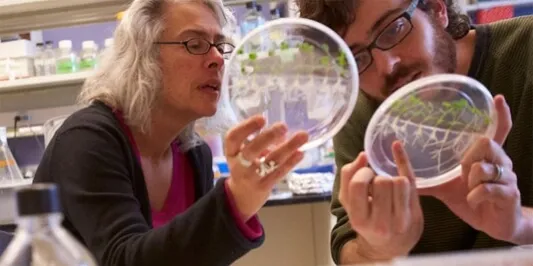

Cell Physiology
The cell is the fundamental building block of life. Members of the Biology department use a variety of approaches to understand cell function, including biochemistry, molecular biology, cell biology, microscopy, electrophysiology, proteomics, and bioengineering. Cell Physiology group members also participate in the Neuroscience and Cell & Molecular Biology graduate programs and they are affiliated with the Vermont Biomedical Research Network Proteomics Core Facility and Bioinformatics Core Facility.
Faculty: Bryan Ballif, Bin Deng, Alicia Ebert, Ying Wai Lam, Molly Stanley, Leo Tang, and Jim Vigoreaux.
Sensory Biology
Sensory systems provide a fundamental link between organisms and their environment. The Biology department includes multiple faculty whose research programs focus on molecular mechanisms, signal transduction, neural processing and behavior of a diverse set of sensory systems. The Sensory Biology group is affiliated with the Neuroscience graduate program and maintains active collaborations with faculty in Communication Sciences and Psychology.
Faculty: Bryan Ballif, Alicia Ebert, Laura May-Collado, Molly Stanley, and Leo Tang.
Social Insect Biology
The social insects are one of the most ecologically dominant groups of organisms in nearly every terrestrial habitat on earth. Research on social insects in the biology department intersects with a range of biological disciplines, facilitating integrative investigations of ecological, evolutionary, and mechanistic questions. Current projects include community assembly, the role of social insects in ecosystem patterns and processes, the evolution of social behavior within and across species, invasive species ecology, and proteomic, biomechanical and genetic mechanisms underlying social traits. Members of the Social Insect group have collaborations across UVM as well as with faculty at other US and international institutions.
Faculty: Sara Helms Cahan and Nicholas Gotelli.
Evolutionary Biology
The department has strengths in both theoretical and empirical aspects of evolutionary biology. Topics of interest include evolutionary genomics, molecular evolution, molecular ecology, phylogenetics, evolutionary and ecological physiology, and disease ecology. Members of the Evolutionary Biology group collaborate with faculty in the departments of Computer Science and Mathematics, Vermont Biomedical Research Network, Vermont Advanced Computing Center, College of Engineering and Mathematical Sciences, and the Rubenstein School of the Environment, as well as with faculty at other US and international institutions.
Faculty: Sara Helms Cahan, Nicholas Gotelli, Elise Lauterbur, Brent Lockwood, Laura May-Collado, Joaquin Nunez, and Melissa Pespeni.
Ecological Parasitology
Parasites and pathogens are important drivers of evolutionary dynamics, and understanding how parasites interact with their hosts and vectors is vital for the fields of epidemiology and public health. Faculty in the Department of Biology study pathogens of major economic and medical importance, including malaria (Plasmodium spp.), using population genetic and evolutionary ecology approaches to investigate the role of parasite genetic diversity in host-parasite interactions. Members of the Ecological Parasitology group collaborate with faculty in the College of Engineering and Mathematical Sciences and School of Natural Resources as well at other US and international institutions.
Faculty: Elise Lauterbur and Ellen Martinsen.
Population and Community Ecology
Species coexist and interact with many other species in nature. Understanding how biological communities form and function, the nature and strength of interspecific interactions, and the ways in which biologists can detect and evaluate such processes in natural systems are all subjects of active research in the Biology department. Faculty in the Community Ecology research group collaborate with researchers at a variety of US and international institutions.
Faculty: Sara Helms Cahan, and Nicholas Gotelli.